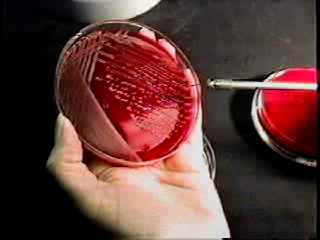

Έλληνας ανακάλυψε νέα συνθετικά αντιβιοτικά κατά του MRSA
Μια νέα κατηγορία συνθετικών αντιβιοτικών που είναι ικανά να καταστρέψουν τον ανθεκτικό στα αντιβιοτικά χρυσίζοντα σταφυλόκοκκο (MRSA), ανακάλυψε ο καθηγητή Ιατρικής, Μικροβιολογίας και Ανοσολογίας, Ελευθέριος Μυλωνάκης του Πανεπιστημίου Μπράουν του Ρόουντ Αϊλαντ.

Αριθμός Πιστοποίησης Μ.Η.Τ.232442
Αριθμός Πιστοποίησης Μ.Η.Τ.232442